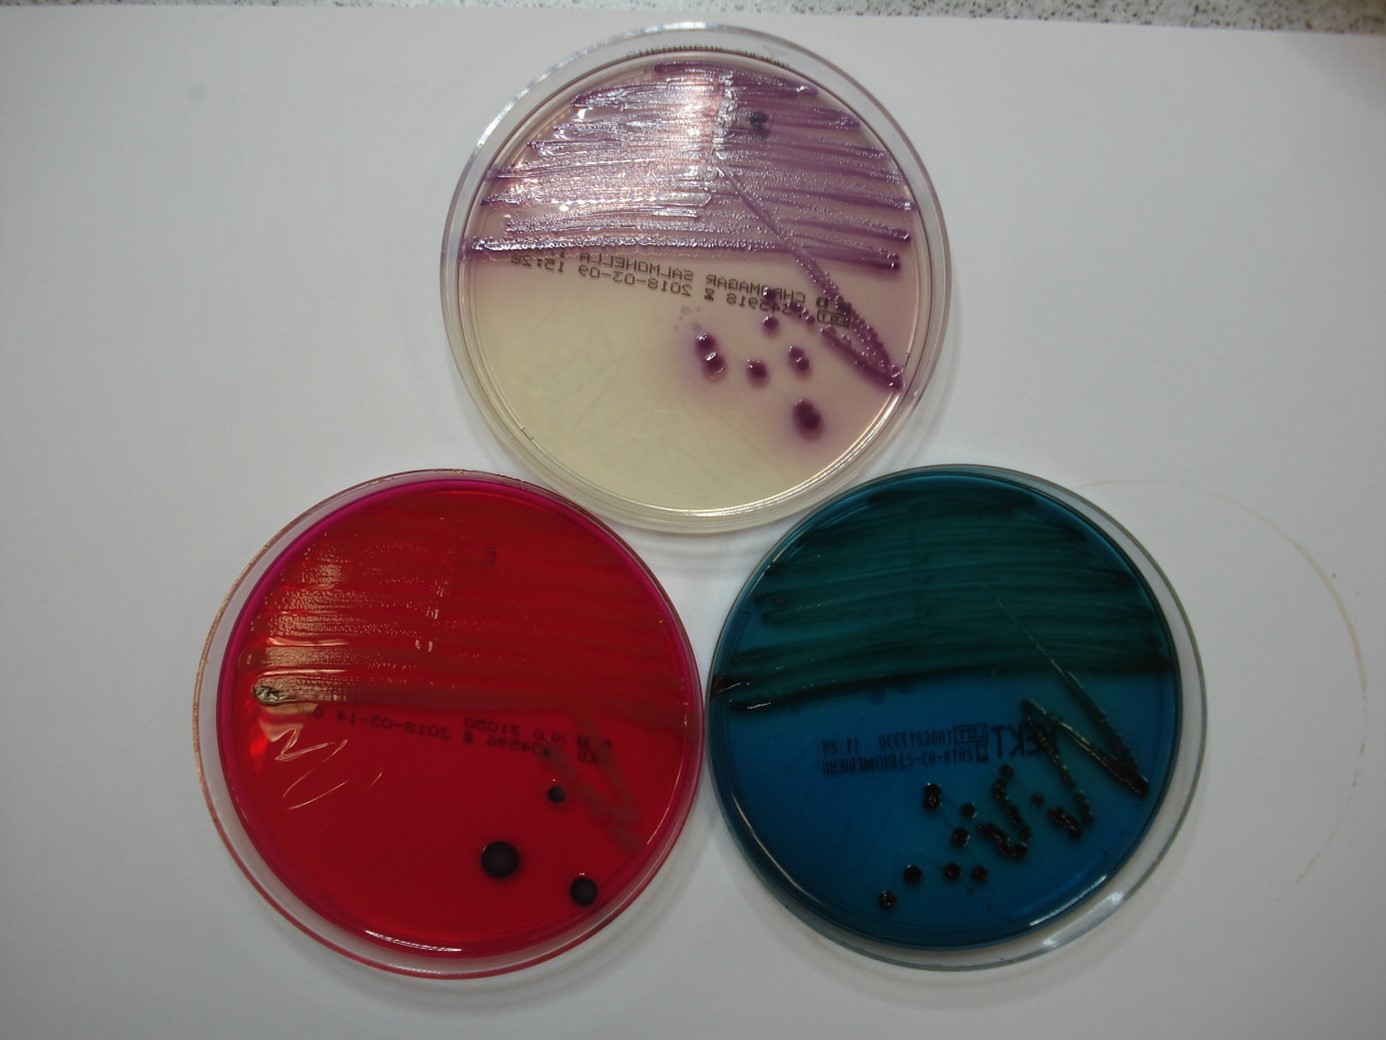

Inhalt

Die Diagnosefindung bei Patienten mit chronischen Enteropathien ist oft nicht einfach. Im Folgenden werden labordiagnostische Möglichkeiten der Kotuntersuchung vorgestellt, die zur Ursachenabklärung beitragen können.
Einleitung
Hunde und Katzen mit Verdauungsstörungen werden häufig in der Kleintierpraxis vorgestellt.
Klassisch sind sporadisch auftretende, selbstlimitierende Durchfallerkrankungen, die rein symptomatisch behandelt werden können und im Verlauf keine weiteren Beschwerden nach sich ziehen. Sind die Durchfallerkrankungen jedoch chronisch, ist der Leidensdruck oft groß.
Folgende Symptome können auftreten: Erbrechen, Durchfall, abdominale Schmerzhaftigkeit, Darmgeräusche, Flatulenz, Gewichtsverlust sowie Inappetenz oder auch Polyphagie.
Die Diagnosefindung kann hier mitunter herausfordernd sein, da viele Ursachen in Frage kommen. Häufig kommen Futtermittelintoleranzen / -unverträglichkeiten oder auch Fütterungsfehler vor. Aber auch Infektionserreger (Parasiten, Bakterien, Viren, selten Prototheken), Obstruktionen, Neoplasien, Toxine, verschiedene Medikamente und Stress können verantwortlich sein. Außerdem kommt auch eine Reihe extraintestinaler Erkrankungen in Betracht, die sekundär Verdauungsstörungen auslösen können. Dies sind vor allem Erkrankungen von Pankreas, Leber, Niere und Schilddrüse oder bei der Katze auch FIV- und FeLV-Infektionen.
Eine weitere Schwierigkeit der Diagnostik liegt darin, dass es nicht immer nur „die eine Erkrankung“ sein muss. Regelmäßig werden auch multimorbide Patienten vorgestellt wie beispielsweise der Futtermittelallergiker mit exokriner Pankreasinsuffizienz.
Unverzichtbar bei der Betreuung von Patienten mit chronischen Enteropathien ist eine gründliche Anamnese mit anschließend sorgfältiger und gut geplanter diagnostischer Aufarbeitung. Auch hier gibt es wieder eine Fülle von Möglichkeiten. Im Folgenden soll es nun um Kotuntersuchungen gehen – ein wertvolles Puzzleteil in der Diagnosefindung. Der größte Vorteil der koprologischen Diagnostik liegt in der einfachen, nicht-invasiven Gewinnung des Probenmaterials.
Kotprobendiagnostik
Folgende labordiagnostische Möglichkeiten stehen zur Verfügung:
- Parasitologische Kotuntersuchung
- Mikrobiologische Kotuntersuchung
o Virologische Kotuntersuchung
o Kulturelle Kotuntersuchung - Dysbioseanalyse
- Fäkale Biomarker
Parasitologische Kotuntersuchung
Die parasitologische Untersuchung einer 3-Tage-Sammelkotprobe sollte standardmäßig bei jedem Durchfallgeschehen durchgeführt werden, da auch bei klinisch gesunden Tieren Parasitenstadien gefunden werden können. Vor allem Nematoden, wie Spul- Haken-, Haar- und Peitschenwürmer sowie Protozoen (z.B. Giardien, Kokzidien, Cryptosporidien) können gastrointestinale Störungen verursachen. Nur in Ausnahmefällen für ein Durchfallgeschehen ursächlich sind hingegen Bandwürmer. Trotzdem sollten sie aufgrund ihres Zoonosepotenzials nicht unterschätzt werden.
Die parasitologische Kotuntersuchung kann ein Nativpräparat, verschiedene Anreicherungsmethoden wie Flotations- und Sedimentationsverfahren, einen Enzyme-linked Immunosorbent Assay (ELISA), einen Immun-Fluoreszenz-Antikörpertest (IFAT), eine Polymerase-Kettenreaktion (PCR) und selten auch eine kulturelle Anzucht umfassen (Tab. 1).
Bei der parasitologischen Untersuchung ist nur ein positiver Befund beweisend.
Merke
Eine Sammelkotprobe von 3 Tagen oder von 3 Defäkationen erhöht die Sensitivität der parasitologischen Untersuchung.
| Parasiten | Parasitologische Untersuchung (Flotation & Sedimentation) | PCR | EIA | IFAT | Kotausstrich | Kultur |
|---|---|---|---|---|---|---|
| Nematoden (Haken-, Spul-, Peitschenwürmer) | + | - | - | - | - | - |
| Giardien | + | + | + | + | (+) (1) | - |
| Kokzidien | + | - | - | - | - | - |
| Tritrichomonas foetus | - | + | - | - | (+) (1) | (+) (2) |
| Cryptosporidien | - | + | + | + | + (3) | - |
(1) Nur aus Frischkot im Direktausstrich möglich, geringe Sensitivität
(2) Nur aus körperwarmem, frischem Kot möglich
(3) unter Anwendung geeigneter Färbungen, z.B. Ziehl-Neelsen
Hakenwürmer (Uncinaria stenocephala (Hund, selten Katze), Ancylostoma caninum (Hund), Ancylostoma tubaeformae (Katze))
Hakenwürmer heften sich mit ihrer Mundöffnung an die Darmschleimhaut und schädigen die Schleimhautoberfläche. Es kommt zu Durchfall. Ancylostoma spp. saugen Blut und können daher bei persistierendem oder starkem Befall eine Anämie hervorrufen. Uncinaria spp. sind weniger pathogen, sie nehmen überwiegend Gewebsbestandteile auf.
Spulwürmer (Toxocara spp., Toxascaris leonina)
Toxocara spp. (Abb. 1) können insbesondere bei Welpen schwerwiegende Erkrankungen hervorrufen – ein Befall ist aber in allen Altersklassen zu beachten. Der Durchfall kann Schleim- und/oder Blutbeimengungen enthalten. Es kann zu Obstipation und Erbrechen kommen. Sind Jungtiere hochgradig befallen, kommt es zu einem umfangsvermehrten, schmerzhaften Abdomen, dem sog. Askaridenbauch. Bei einer Infektion mit Toxascaris leonina sind die Verläufe meist milder.

Peitschenwurm (Trichuris vulpis)
Umgebungen mit hoher Besatzdichte, wie Tierheime, können massiv mit Eiern von Trichuris vulpis kontaminiert sein, was das Risiko für Reinfektionen wesentlich erhöht. Bei Hunden können klinische Symptome auftreten: Blutiger, schleimiger Durchfall, Erbrechen, evtl. Gewichtsverlust. Bei massivem Befall kann es zu Hyponatriämie und Proteinverlust kommen.
Giardien (Giardia duodenalis)
Während Giardieninfektionen bei adulten Hunden und Katzen meist symptomlos verlaufen, zählen sie bei den Jungtieren im ersten Lebensjahr zu den häufigsten Endoparasitosen. Auch treten sie gerne gleichzeitig mit anderen Infektionserregern auf. Beschrieben sind chronisch intermittierende Durchfälle mit Schleimbeimengungen, die von dünnbreiiger bis wässriger Konsistenz sind. Der Nachweis von Kopro-Antigen hat den Vorteil, dass auch dann eine Infektion nachgewiesen werden kann, wenn eine Zystenausscheidung vorübergehend ausbleibt. Nachteilig ist die hohe Sensitivität der Antigennnachweise allerdings, wenn der Therapieerfolg kontrolliert werden soll. Um falsch positive Ergebnisse zu vermeiden, müssen nach erfolgter Therapie min. 3 Wochen abgewartet werden. Wenn schon früher getestet werden soll, eignen sich eher die parasitologische Untersuchung oder der IFAT.
Kokzidien (Isospora spp.)
Klinisch erkranken überwiegend Hunde- und Katzenwelpen, aber auch ältere Tiere können sich durch die Aufnahme infektiöser Oozysten infizieren. Die Erkrankungen können subklinisch verlaufen oder Verdauungsstörungen hervorrufen. I. felis und I. canis können aber gerade bei Welpen blutige Durchfälle verursachen, die bei schwerwiegenden Verläufen zum Tod führen können. Kokzidien lassen sich in der parasitologischen Untersuchung gut darstellen.
Tritrichomonas foetus
Der Erreger kolonisiert die Kolonmukosa von Katzen und führt zu chronischer Dickdarmdiarrhö. Junge Katzen, die in einem Mehrkatzenhaushalt leben, sind besonders gefährdet. Bei persistierenden Infektionen kommt es zu einer intermittierenden Symptomatik, die insbesondere in Stresssituationen aufflammen kann. Weicher bis flüssiger Kot mit Schleim- und Blutbeimengungen kann auftreten. Es zeigt sich eine erhöhte Kotabsatzfrequenz bis hin zu Kotinkontinenz. Die PCR ist die Methode der Wahl für den direkten Erregernachweis.
Cryptosporidien (C. parvum, C. canis, C. felis)
Bei adulten, immunkompetenten Tieren verläuft eine Infektion i.d.R. symptomlos. Welpen können jedoch an wässrig, oftmals stinkendem Durchfall erkranken, der gelegentlich auch mehrere Wochen lang andauern kann. Meist kommt es zu einer spontanen Heilung. Cryptosporidien-Oozysten besitzen eine überaus hohe Tenazität. So bleiben sie in der Außenwelt lange infektiös und sie können nur von bestimmten Desinfektionsmitteln abgetötet werden. Geeignete Nachweismethoden sind vor allem die Kopro-Antigen-Nachweise. Darüber hinaus kann man die Oozysten aber auch in Kotausstrichen mithilfe besonderer Färbemethoden (z.B. Ziehl-Neelsen) darstellen. Eine Artunterscheidung ist jedoch nur molekularbiologisch möglich. (ESCCAP 2017, 2014)
Virologische Kotuntersuchung
Bei gastrointestinaler Symptomatik können folgende Viren bei Jungtieren häufig nachgewiesen werden: Parvo-, Circo-, Corona- und Rotaviren. Allerdings verlaufen viral bedingte Durchfallgeschehen meist akut. Bei chronischen Enteropathien scheinen sie hingegen keine wichtige Rolle zu spielen, weshalb an dieser Stelle nicht weiter auf die Diagnostik viraler Durchfallerreger eingegangen wird.
Bakteriologische Kotuntersuchung
Eine bakteriologische Kotuntersuchung kann einen ersten Überblick geben. Sie ist erforderlich, wenn der behandelnde Tierarzt eine Antibiotikatherapie für notwendig hält und für die Therapieplanung ein Antibiogramm benötigt, bzw. verlangen auch gesetzliche Vorgaben unter bestimmten Bedingungen die Erstellung eines Antibiogramms.
Weiterhin besteht nach kultureller Anzucht die Möglichkeit, aus den isolierten Bakterien einen individuell auf das Tier zugeschnittenen bestandsspezifischen Impfstoff (Autovakzine) herzustellen.
Mit einer kulturellen Kotuntersuchung werden auch fakultativ darmpathogener Erreger nachgewiesen. Hierbei ist es wichtig zu beachten, dass diese besondere Kulturbedingungen/Testverfahren benötigen und daher extra angefordert werden müssen - dazu gehören: Salmonellen, Campylobacter spp., Yersinien, Listerien, toxinproduzierende Clostridien, enteropathogene Escherichia coli. Alle genannten Keime können auch bei klinisch gesunden Tieren nachgewiesen werden, ihre Pathogenität ist teilweise umstritten (Westermarck 2016). Besonders häufig werden sie im Kot von Tieren, die nach dem Barf-Prinzip gefüttert werden, gefunden. Da es sich bei einigen um Zoonoseerreger handelt, empfiehlt sich eine regelmäßige Abklärung.
Merke
Ein spezieller Keimverdacht sollte bei der diagnostischen Abklärung der Kotprobe unbedingt mit angegeben werden.
Salmonellen (Abb. 2)
Salmonelleninfektionen verlaufen bei Hund und Katze meist latent. Bei immunsupprimierten Einzeltieren kann es in seltenen Fällen aber auch zu klinisch manifesten Erkrankungen kommen. Durchfall, Erbrechen, Fieber, Anorexie und Lethargie können mögliche Symptome sein. I.d.R. dauert die Ausscheidung, die auch intermittierend sein kann, ca. 3-4 Wochen. Etwa ein Drittel klinisch gesunder Hunde können asymptomatische Salmonellenausscheider sein, so dass auch Kontakttiere ohne Symptome aus dem gleichen Haushalt mitgetestet werden sollten. Ein positiver Nachweis ist meldepflichtig.
Campylobacter
Campylobacter spp. kommen bei Hunden und Katzen mit und ohne Durchfall vor. C. jejuni kann v.a. bei Jungtieren unter 6 Monaten Diarrhoe auslösen. Hier reicht die Symptomatik von gelegentlich weichem Kot bis zur hochgradig wässrigen und auch hämorrhagischen Diarrhoe, teils mit Schleimbeimengungen. Auch kann es zu Erbrechen kommen.
Thermophile Campylobacter-Spezies sind meldepfichtig, hierzu gehören C. jejuni, C. coli, C. lari und C. upsaliensis.
Yersinien
Y. enterocolitica und Y. pseudotuberculosis können als Darmbewohner bei gesunden Tieren vorkommen, aber auch zu chronischer Kolitis mit blutig, schleimigem Durchfall führen. Eine erhöhte Kotabsatzfrequenz mit Tenesmus kann ebenfalls beobachtet werden. Jungtiere sind häufiger betroffen. In seltenen Fällen kann es außerdem zu Allgemeinerkrankungen wie Fieber oder Arthritis kommen.
Listerien
Von Listeria monocytogenes gibt es verschiedene Serovare, aber nur wenige sind pathogen. Im Vergleich zu anderen Haustieren erkranken Hunde und Katzen nur selten an Listeriose, Katzen wird eine erhöhte Resistenz gegenüber Listerien nachgesagt. Zu den Symptomen gehören v.a. Durchfall, Vomitus und Fieber. Zusätzlich können zentralnervöse Störungen auftreten. Für den Nachweis von Listeria monocytogenes besteht eine Meldepflicht.
Clostridien
Clostridien sind Vertreter des intestinalen Mikrobioms und erfüllen teilweise wichtige Aufgaben. Einige Stämme sind jedoch in der Lage, Toxine zu bilden, die Erkrankungen auslösen können. Zu nennen sind das Enterotoxin (cpe) von Clostridium perfringens und die Toxine A und B von Clostridioides difficile. Außerdem werden die Toxine netE und netF im Zusammenhang mit dem Akuten Hämorrhagischen Diarrhoe-Syndrom (AHDS) bei Hunden genannt.
Escherichia coli
Auch E. coli ist Bestandteil des physiologischen intestinalen Mikrobioms. Als Durchfallerreger sind bei Hunden die Stämme EPEC (enteropathogene E. coli), ETEC (enterotoxinogene E. coli) und seltener EHEC (enterohämorrhagische E. coli) beschrieben. Diese kommen aber auch bei klinisch gesunden Tieren vor. Pathogene E. coli besitzen eine Ausstattung an unterschiedlichen Virulenzfaktoren wie beispielsweise Adhäsine, Kapselpolysaccharide und Endotoxine. Mit Hilfe molekularbiologischer Methoden lassen sich verschiedene Pathogenitätsfaktoren von E. coli-Isolaten nachweisen. (Kerner 2023)
| Bakterien | Kultur | ELISA | PCR |
|---|---|---|---|
| Salmonellen | + | - | + |
| Campylobacter | + | - | + |
| Yersinien | + | - | + |
| Listerien | + | - | + |
| Clostridien | (+) (1) | + (2) | + (3) |
| E. coli | + | - | + (4) |
(1) Kultur erfüllt keinen diagnostischen Nutzen, da Normalflora. Die Bestimmung der Gesamtheit gasbildender Bakterien ist im Hochschichtagar möglich
(2) Nachweis von cpe und der Toxine A und B
(3) Gennachweis von Stämmen, die netE und netF bilden können
(4) Gennachweis von Pathogenitätsfaktoren (STa, STb, LTb, Stxt, Stx2, eae)
Nicht geeignet ist die bakteriologische Kultur hingegen zum Nachweis einer bestehenden Dysbiose, da sich das Darmmikrobiom überwiegend aus anaeroben Bakterien zusammensetzt und die Menge der detektierten Bakterien auch nur semiquantitativ angegeben werden kann.
Dysbioseanalyse
Diese Untersuchung ist PCR-basiert und damit von der Kultivierbarkeit der Bakterien unabhängig. Aus der Kotprobe wird zunächst DNA isoliert. Mittels quantitativer PCR werden im Anschluss spezifische Markerkeime gemessen, die einen Rückschluss auf den Zustand der Darmmikrobiota erlauben.
Die Dysbioseanalyse dient in erster Linie der Diagnostik von Darmdysbiosen. Sie ermöglicht eine prognostische Einschätzung, inwieweit eine Fäkaltransplantation (Fäkale Mikrobiota-Transplantation = FMT) bei dem entsprechenden Patienten erfolgreich sein könnte und dient der Auswahl geeigneter Kotspender. Auch die Beeinträchtigung des intestinalen Mikrobioms nach Antibiotikatherapie (Pilla et al. 2020; Manchester et al. 2019) kann sichtbar gemacht werden. Möglicherweise kann auch bei Störungen des Immunsystems (Tizard und Jones 2018) wie beispielsweise Futtermittelunverträglichkeiten (Craig 2019), bei Vorliegen von Stoffwechselstörungen (Kim et al. 2023) oder Verhaltensauffälligkeiten (Mondo et al. 2020; Kirchoff et al. 2019) die Dysbioseanalyse zukünftig hilfreich sein – hier bedarf es jedoch weiterer Studien.

Fäkale Biomarker
Canine Pankreas-Elastase E1
Die quantitative Messung des Enzyms Pankreas-Elastase (PE) aus dem Kot mittels ELISA kann bei Hunden als Screeningtest für eine exokrine Pankreasinsuffizienz (EPI) verwendet werden. Die Bestimmung der PE ist auch während einer Enzymtherapie möglich, da diese keinen Einfluss auf das Ergebnis hat. Flüssige Kotproben eignen sich jedoch nicht für diese Untersuchung, da es durch den Verdünnungseffekt zu falsch niedrigen Ergebnissen kommen kann. Erniedrigte Werte weisen auf eine EPI hin, kommen aber auch bei gesunden Hunden vor, weshalb eine verminderte Elastasekonzentration im Kot durch die Bestimmung von TLI (Trypsin-like Immunreactivity) aus dem Serum kontrolliert werden sollte (Steiner 2012).
(Gesamt-)Gallensäuren
Gallensäuren können mittels ELISA quantitativ im Kot bestimmt werden. Sie werden als Endprodukt des Cholesterinstoffwechsels in das Duodenum sezerniert. Im enterohepatischen Kreislauf werden die Gallensäuren im Ileum wieder resorbiert und werden der Leber zugeführt. Nur ein geringer Teil wird somit über den Kot ausgeschieden. Zu erhöhten Werten kommt es bei verminderter Resorptionsleistung, die etwa durch eine verkürzte Darmpassage oder einen bacterial overgrowth im Dünndarm (SIBO) bedingt sein kann.
Calprotectin
Calprotectin ist ein Kalzium-bindendes Protein mit antimikrobiellen Eigenschaften, das als Marker für neutrophile Entzündungen angesehen wird. Studien haben gezeigt, dass es in Fäzes von Hunden mit chronischen Enteropathien erhöht ist (Enderle et al. 2022). Auch bei gesunden Welpen ist es im Kot erhöht. Calprotectin gilt als ein Entzündungsmarker, der relativ gut mit dem Entzündungsgrad korreliert. Somit ist dieser Biomarker auch zur Kontrolle des Therapieverlaufes bei chronisch entzündlichen Enteropathien geeignet. (Grellet et al. 2013)
α-1-Antitrypsin (auch: AAT, Alpha-1-Proteinase-Inhibitor)
Hierbei handelt es sich um ein Plasmaprotein, das in der Leber synthetisiert und in den Blutkreislauf abgegeben wird, um Gewebeschäden durch Entzündungen zu reduzieren. Da es ein hohes Molekulargewicht besitzt, kann es die intakte Darmbarriere nicht überwinden. Ist sie allerdings geschädigt, wie beispielsweise bei einer Proteinverlust-Enteropathie (protein-losing enteropathy, PLE) gehen Proteine über die entzündete Mukosa verloren. Bei Tieren, die eine Hypoproteinämie zeigen und gleichzeitig gastrointestinale Symptome haben, sollte eine PLE stets abgeklärt werden. Zu beachten ist allerdings, dass es sich bei α-1-Antitrypsin nicht um einen spezifischen Marker handelt. Vielmehr kann die Barrierefunktion beurteilt werden (Ruaux 2011). Erhöhte Werte kommen bei allen gastrointestinalen wie systemischen Erkrankungen vor, die zu einer erhöhten Darmpermeabilität führen.
Sekretorisches Immunglobulin A (sIgA)
Das sekretorische Immunglobulin A ist Bestandteil des adaptiven und Schleimhaut-assoziierten Immunsystems und kommt u.a. auch in Verdauungssäften vor. Es bindet an Antigene und verhindert somit ihre Anheftung an die Schleimhautzellen. Erniedrigte Werte können auf eine verringerte Dichte immunstimulierender, bzw. – modulierender Darmmikrobiota hindeuten. Dies könnte beispielsweise bei chronisch entzündlichen Enteropathien oder rezidivierenden Infekten der Darmschleimhaut zutreffen. Erhöhte Werte hingegen sprechen für eine gesteigerte Immunantwort, die durch enteropathogene Erreger oder auch Nahrungsmittelallergene hervorgerufen werden könnte.
Fazit
Kotuntersuchungen gehören bei der Aufarbeitung von Patienten mit chronischen Enteropathien oft mit zu den ersten diagnostischen Maßnahmen. In manchen Fällen können Sie invasivere Methoden entbehrlich machen, jedoch sollten die Untersuchungsergebnisse nicht für sich allein, sondern immer auch im Zusammenspiel mit der Anamnese, der klinischen Untersuchung und evtl. weiteren vorliegenden Untersuchungsergebnissen (Bildgebung, Blutuntersuchungen, etc.) interpretiert werden.
Beitrag aktualisiert am 30.09.2024.
Der Originalbeitrag zum Nachlesen:
Bismarck, D. Kotuntersuchungen bei chronisch-entzündlichen Darmerkrankungen. kleintier konkret 2018; 21(06): 35-39 DOI: 10.1055/a-0579-1050
(JD)
- Craig J M. (2019): Food intolerance in dogs and cats. J Small Anim Pract, 60(2), 77-85. DOI: 10.1111/jsap.12959
- Enderle L L, Köller G und Heilmann R M. (2022): Verification of the fCAL turbo immunoturbidimetric assay for measurement of the fecal calprotectin concentration in dogs and cats. J Vet Diagn Invest, 34(5), 813-824. DOI: 10.1177/10406387221114031
- ESCCAP. (2014). Bekämpfung von Würmern (Helminthen) bei Hunden und Katzen. Deutsche Adaptation der ESCCAP-Empfehlungen Nr. 1. Abgerufen am 19.09.2024, 2024. Verfügbar unter www.esccap.de/v2/wp-content/uploads/2020/06/2-2022-Helminthen-Empfehlung-1.pdf
- ESCCAP. (2017). Bekämpfung von intestinalen Protozoen bei Hunden und Katzen. Deutsche Adaptation der ESCCAP-Empfehlung Nr. 6. Abgerufen am 19.09.2024, 2024. Verfügbar unter www.esccap.de/v2/wp-content/uploads/2020/09/2-2022-Protozoen-Empfehlung-6.pdf
- Grellet A, Heilmann R M, Lecoindre P, Feugier A, Day M J, Peeters D, Freiche V, Hernandez J, Grandjean D, Suchodolski J S und Steiner J M. (2013): Fecal calprotectin concentrations in adult dogs with chronic diarrhea. Am J Vet Res, 74(5), 706-711. DOI: 10.2460/ajvr.74.5.706
- Kerner K. (2023): Escherichia coli als Durchfallerreger bei Hunden. kleintier konkret, 26(06), 31-34. DOI: 10.1055/a-2177-4670
- Kim J H, An J H, Lee J H, Park S M, Lim G H, Oh Y I, Seo K W und Youn H Y. (2023): Changes in Lactate-related Fecal Microbiome in Hyperlactatemia Diabetic Dogs. In Vivo, 37(2), 696-701. DOI: 10.21873/invivo.13130
- Kirchoff N S, Udell M A R und Sharpton T J. (2019): The gut microbiome correlates with conspecific aggression in a small population of rescued dogs (Canis familiaris). PeerJ, 7, e6103. DOI: 10.7717/peerj.6103
- Manchester A C, Webb C B, Blake A B, Sarwar F, Lidbury J A, Steiner J M und Suchodolski J S. (2019): Long-term impact of tylosin on fecal microbiota and fecal bile acids of healthy dogs. J Vet Intern Med, 33(6), 2605-2617. DOI: 10.1111/jvim.15635
- Mondo E, Barone M, Soverini M, D'Amico F, Cocchi M, Petrulli C, Mattioli M, Marliani G, Candela M und Accorsi P A. (2020): Gut microbiome structure and adrenocortical activity in dogs with aggressive and phobic behavioral disorders. Heliyon, 6(1), e03311. DOI: 10.1016/j.heliyon.2020.e03311
- Pilla R, Gaschen F P, Barr J W, Olson E, Honneffer J, Guard B C, Blake A B, Villanueva D, Khattab M R, AlShawaqfeh M K, Lidbury J A, Steiner J M und Suchodolski J S. (2020): Effects of metronidazole on the fecal microbiome and metabolome in healthy dogs. J Vet Intern Med, 34(5), 1853-1866. DOI: 10.1111/jvim.15871
- Ruaux C G. (2011): Laboruntersuchungen zur Diagnostik von Enteropathien. In M. Steiner (Hrsg.), Gastroenterologie bei Hund und Katze (S. 51-56). Hannover: Schlütersche.978-3-89993-060-3
- Steiner J M. (2012): Erkrankungen des exokrinen Pankreas. In P. F. Suter, B. Kohn & G. Schwarz (Hrsg.), Praktikum der Hundeklinik (Bd. 11, S. 767-772): Enke.978-3-8304-1125-3
- Tizard I R und Jones S W. (2018): The Microbiota Regulates Immunity and Immunologic Diseases in Dogs and Cats. Vet Clin North Am Small Anim Pract, 48(2), 307-322. DOI: 10.1016/j.cvsm.2017.10.008
- Westermarck E. (2016): Chronic Diarrhea in Dogs: What Do We Actually Know About It? Top Companion Anim Med, 31(2), 78-84. DOI: 10.1053/j.tcam.2016.03.001



